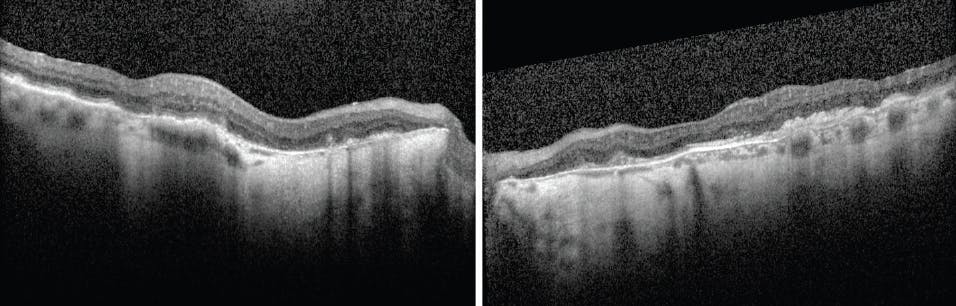

We’ve entered a new phase of retina practice now that drugs that treat geographic atrophy (GA) have been approved by the US Food and Drug Administration (FDA). For those of us who have embraced these GA treatments, this means that we have set up protocols and standards of care in our clinics; for those who are waiting to incorporate treatments into their clinics, they have waited to see how their colleagues have fared.
To that end, I sat down with two high-volume retina specialists—Lisa J. Faia, MD, and Christopher D. Riemann, MD—both of whom have thought deliberately about how to incorporate these treatments into their clinics. We recorded a pair of podcast episodes on New Retina Radio and a set of four videos for Eyetube.net and adapted our discussion to this print piece. Watch the patient case videos and listen to the podcasts scattered in the relevant areas of this discussion to learn more.
—David RP Almeida, MD, MBA, PhD, DABO, FRCSC, FASRS
Patient Selection
David RP Almeida, MD, MBA, PhD, DABO, FRCSC, FASRS: Patient selection is key to success when treating patients with GA, but our field is still figuring out which patients are suited for treatment. Which clinical characteristics do you lean on when determining a patient’s suitability for therapy?
Lisa J. Faia, MD: Patients who experience vision loss due to GA and have no other ocular pathology are excellent candidates for GA treatment. Of course, many of our patients have GA in the presence of other ocular conditions, and a large percentage of those patients are still good candidates for treatment.
But subjective reports of vision loss aren’t the only (or even the best) marker for whether a patient should undergo GA treatment. I screen many patients in my clinic using fundus autofluorescence (FAF) imaging, and I find eyes with extrafoveal GA lesions that have not yet encroached upon the fovea or have not grown large enough to meaningfully alter a patient’s vision. I consider these patients great candidates for early intervention.
Christopher D. Riemann, MD: My treatment models continue to evolve as my experience with GA treatment grows. I was slower to embrace GA treatments than some of my colleagues, but I have been using them in more patients as I gain a sense of who is a good fit for therapy.
I have found that patients with bilateral GA but only monofocal vision disruption understand the stakes of treatment. They know that GA can claim vision if left unchecked, and they are often enthusiastic about undergoing treatment in their better-seeing eye. In these patients, treatment may mean the difference between slowing the progression of GA so significantly that they remain independent versus losing functional vision entirely.
Dr. Faia: Patients with simultaneous ocular diseases that could affect their vision (eg, glaucoma, neovascular disease, diabetic eye disease) require a bit more chair time so that we can educate them about the source of their declining vision. They may not intuitively understand that loss of central vision is linked to GA (which they may not have known about or been previously diagnosed with) and not, say, their long-standing glaucoma.
Dr. Riemann: Chair time with GA patients is critical. The conversations about GA treatment need to be nuanced and often hinge upon the psycho-social elements of care at least as much as on the biological disease state and its underlying mechanisms. Those conversations are a challenge: on a busy clinical day where I am tasked with seeing dozens of patients many of whom present with immediately blinding diseases such as retinal detachment, complications of anterior segment surgery, or retinal vascular disease, every minute matters. In my clinic, I rely on an optometrist to have discussions about GA disease pathology and treatment options. Partnering with an optometrist has given me some time back, but I nevertheless remain busy.
Dr. Almeida: I am still at the point where I ask patients if their activities of daily living or their hobbies are affected by vision disruption. If the answer is yes, then I consider introducing GA treatment. These patients are often motivated to present for treatment. What have you found motivates patients to adhere to recommended dosing schedules?
Dr. Faia: Patients who understand the stakes of vision loss due to GA are among the most motivated individuals in my clinic. It’s important to keep that in mind when selecting patients for GA treatment: Those who aren’t going to present for regular dosing may not be good candidates.
Dr. Almeida: We need to remember that the motivations of patients with GA to adhere to treatment schedules differ from those of patients with other retinal diseases, such as wet age-related macular degeneration (AMD) or diabetic macular edema (DME). Our field has a decade of experience with VEGF-driven disease, and patients with those conditions primarily want to restore vision, which they may achieve with as-recommended dosing. GA patients are motivated to arrest or significantly slow vision loss and do not expect to have their vision restored (as long as providers correctly set their expectations).
Deciding to Treat
Dr. Almeida: How long do you prefer to see a patient before initiating GA treatment?
Dr. Riemann: I like to see evidence of disease progression in GA patients before I treat them, so if a patient presents to my clinic without any imaging history, I want to see measurable progression over at least two visits over the span of at least 3 months before deciding whether GA treatment is right for them.
Dr. Faia: I ask patients with newly diagnosed GA to return in 3 to 6 months. If I see evidence of progression, then I begin discussions about treatment options. But if their GA lesion is stable and their vision hasn’t changed in the span between their two appointments, then I include the possibility of monitoring their condition during the discussion on next steps. Regular injections are a large burden, and for some patients, they may be too disruptive. Also, injections carry a risk of endophthalmitis and other complications, so I exercise caution in patients who aren’t showing signs of GA progression.
Dr. Almeida: I want to hear more about the specifics of your treatment discussions. What elements of treatment do you find patients are most curious about? And which details about treatment do you focus on most?
Dr. Riemann: Safety considerations are a major part of my treatment discussions. After spending time on the internet, some of my GA patients are aware of real-world safety issues surrounding pegcetacoplan (Syfovre, Apellis Pharmaceuticals). If they bring up those concerns, or if they are generally more risk-averse, I refocus the conversation toward avacincaptad pegol (Izervay, Astellas). Having experience with both therapies means I can maximize offerings to my patients by tailoring treatment to their specific needs and risk tolerance.
Dr. Faia: Setting expectations about the lifelong commitment to therapy is a major focus for me. I tell patients one-and-done treatments do not exist for GA, and that consistent dosing will be needed for as long as they’re able to make it to the clinic. The label for avacincaptad pegol allows dosing every 28 days ± 7 days, which makes it a better fit for patients who are committed to presenting to the clinic as scheduled.1
When patients hear that there are two drugs that treat GA, they are relieved to hear that I use both options. I tailor my choice based on the patient’s ability to adhere to the dosing regimen outlined in the FDA labeling. Knowing that options exists—however limited—is a relief to many patients.
Dr. Almeida: Managing outcomes expectations can be a challenge when treating GA. How do you prepare patients for the range of outcomes if treatment is initiated?
Dr. Riemann: We have robust datasets from the pivotal clinical trials evaluating the safety and efficacy of both GA treatment options, which can inform the expectations we set for patients. Still, experience tells us that there is typically a disconnect between real-world outcomes and clinical trial outcomes. We can’t easily or accurately extrapolate data from tightly controlled clinical trials to the diverse and heterogenous patients in our waiting rooms.
Knowing that, I keep my outcomes expectations broad. I tell patients that we have safe treatment options that might lead to slowed rates of vision loss. I don’t make promises.
Real-World Case: Balancing Treatment Burden With Expectations of Vision Loss
Dr. Faia: An 81-year-old White woman presented to the clinic following bilateral cataract extraction. Her past medical history included hypertension, atrial fibrillation, osteoporosis, transient ischemic attack, and hyperlipidemia; her past surgical history included hip and knee replacements. In addition to cataract surgery, the patient had a history of bilateral dry eye and bilateral posterior vitreous detachment.
Clinical examination revealed BCVA 20/25 OU, evidence of hypertransmission on OCT imaging, and extrafoveal lesions in both eyes as seen on FAF imaging (Figure 1). The patient was told to return in 6 months but was lost to follow-up (LTFU). In my experience, LTFU status in patients with dry AMD or GA sometimes occurs because patients experience no subjective vision loss, and therefore feel no need to return.

Figure 1. Upon presentation, extrafoveal lesions in the right eye (A) and left eye (B) were observed on FAF imaging. OCT imaging showed some evidence of hypertransmission associated with GA. BCVA was 20/25 OU.
When the patient presented again 2 years after her initial examination, she reported subjective vision loss. FAF imaging revealed significant growth of GA lesions in both eyes (Figure 2). Surprisingly, her BCVA was measured at 20/40 OD and 20/25 OS. Foveal encroachment was present OD and was nearly manifest OS.

Figure 2. Two years after her initial examination, the patient returned complaining of vision loss. GA growth was evident OU, with foveal encroachment observed OD, where her BCVA was measured at 20/40 (A). Despite significant lesion growth OS, her BCVA was unchanged from her previous visit and was measured at 20/25 (B).
At this point, no therapies were approved for the treatment of GA. The patient reported that although she had some visual decline, she was still able to read and did not have any issues with activities of daily living. I asked the patient to return in 6 months, at which point it was possible that a treatment for GA would be approved by regulatory bodies.
The patient returned in 5 months with complaints of significant visual decline. Her BCVA was 20/40 OD and 20/30 OD, and foveal involvement as seen on FAF was present OU (Figure 3). By this point, both avacincaptad pegol and pegcetacoplan were approved for the treatment of GA, and I initiated a discussion about treatment options with the patient and her daughter, who had provided transportation to the clinic for past appointments. They decided that burden of care (ie, monthly or every-other-month treatment, risk of infection) was higher than the proposed outcome (ie, potential arrested development of GA lesions), and declined to start therapy. I asked the patient to return in 3 months.

Figure 3. The patient returned to the clinic 5 months after the previous appointment, 1 month earlier than requested. She reported visual decline OS, and her BCVA had decreased from 20/25 OS to 20/30 OS (B). FAF imaging showed that foveal involvement was present OU, and that increased hypertransmission could be observed on OCT on OS as well as OD (A)
The patient and her daughter returned in 6 months. The patient’s vision, although not any different than her last appointment as measured via BCVA, had worsened to the point that she could no longer safely drive (Figure 4). The patient requested treatment, and a plan was put in place to begin a therapeutic regimen.

Figure 4. The patient returned 6 months after her previous appointment; at this point, nearly 3 years had elapsed since her initial presentation. Her BCVA was stable at 20/40 OD (A) and 20/30 OS (B), but the patient’s ability to drive had deteriorated. She opted for anti-complement therapy.
Dr. Almeida: This case illustrates something we often see in GA patients: that although BCVA has not precipitously declined, visual quality has. This reminds us that measuring BCVA may not be as useful in GA as in wet AMD and DME. Her subjective decline in vision is what motivated her to seek treatment finally.
Dr. Faia: That’s correct. At the appointment during which she decided that she wanted treatment, the patient presented 3 months later than she anticipated, in part because she was unable to safely drive to the appointment. At that point, she said she began to understand the potential of a life without independence.
Dr. Riemann: Family members share the burden of care. Explaining to caregivers that monthly or every-other-month visits to a clinic may mean greater independence for both the patient and caretaker on a day-to-day basis sometimes convinces caregivers that the inconvenience of clinical visits is outweighed by the long-term inconvenience of caring for someone with limited vision. In short, you might need to drive your parent to the clinic every month—but that may mean not needing to care for a legally blind loved one every day.
Real-World Case: GA in the Setting of Contralateral Wet AMD
Dr. Riemann: A patient in her mid-70s presented to my clinic with evidence of GA on FAF imaging and disciform scarring OS (Figure 5). This was in 2016, when no treatment options for GA were approved by regulatory bodies. The optometrist with whom I collaborate, Mary Beth Yackey, OD, was instrumental in the management and documentation of this patient’s GA.

Figure 5. Upon presentation, the patient showed evidence of GA on FAF imaging OD (A) and disciform scarring OS (B).
Image courtesy of Mary Beth Yackey, OD.
OCT imaging at presentation showed evidence of GA OD and exudative changes OU (Figure 6). The patient began anti-VEGF treatment for wet AMD OU. Treatment OS was halted after 10 doses because the patient’s vision did not improve (likely due to the disciform scarring seen on presentation) and at her most recent appointment, her BCVA OS was hand movement. Wet AMD treatment OD has included 52 doses, with BCVA OD at 20/70+1 at the most recent appointment. Over the course of 7 years, the patient subjectively reported declining vision OD, which is likely due to the progression of GA lesions in that eye as shown on FAF (Figure 7) and OCT (Figure 8) at her most recent visit.

Figure 6. OCT imaging at presentation showed evidence of wet AMD, which led to the initiation of treatment with anti-VEGF therapy. The patient has received 52 doses of anti-VEGF therapy OD and 10 doses OS; treatment was halted OS due to disciform scarring.
Images courtesy of Mary Beth Yackey, OD.

Figure 7. FAF imaging 7 years after initial presentation showed significant GA lesion growth OD with foveal involvement, which likely has contributed to declining BCVA despite regular anti-VEGF treatment for wet AMD. Advanced disciform scarring is very pronounced OS.
Figure 8. OCT imaging 7 years after initial presentation shows continued GA progression OD. It was determined that complement inhibition treatment was warranted in this patient.
The patient decided that complement inhibition therapy OD was warranted, and now visits the clinic each month for treatment. She receives anti-complement treatment every other month and anti-VEGF on alternate months.
Dr. Almeida: This patient illustrates the challenging cases we face in the real world. Patients sometimes present with only one condition, but they more often present with ocular medical and/or surgical histories that may complicate our efforts to treat the condition for which they present. When this patient presented in 2016, no GA treatments were available. I wonder how your approach might have changed if the patient presented with wet AMD and GA today.
Dr. Riemann: I would still prioritize controlling their exudative disease. Given the safety and efficacy profile of anti-VEGF treatments, I am confident that we can at least control that pathology before considering a complement inhibitor for GA. If I can extend a wet AMD patient to at least 6 weeks, then I begin to think about dosing a complement inhibitor.
I am comfortable dosing anti-VEGF therapy and complement inhibitors in the same visit. Typically, I perform a large paracentesis and then inject both medications in the same location sequentially.
Dr. Faia: I agree that wet AMD needs to be controlled before we can begin treatment for GA. For some patients, we simply need to move through one disease at a time.
I’ve had patients with wet AMD and GA who lost vision despite well-controlled exudative disease. Educating patients that anti-VEGF treatment only addresses one form of AMD is a challenge, and patients often get discouraged that, despite regular injections, they are slowly losing vision.
One patient in particular comes to mind. He had been visiting my clinic for years for wet AMD treatment, and he was still experiencing visual decline from GA. He was patiently awaiting approval of a therapeutic option and was happy to learn of the eventual FDA approval of two different drugs. He was visiting the clinic for wet AMD dosing every 5 weeks, on average, and was willing to add a second injection for his GA when visiting. Injecting two drugs in one session kept the burden of care low, which was important for this patient, who drove 90 minutes each way to visit the clinic.
Dr. Almeida: Like both of you, I prioritize controlling wet AMD in a patient who has both subtypes of advanced AMD. But, I still like to see that a patient has GA progression over time before I administer anti-complement therapy. If they do indeed show some progression of GA, I will suggest treatment. We need to remind ourselves that, in these patients, even if the wet AMD is in the ‘maintenance’ phase, the GA is in an active dosing phase.
How do you educate patients with both wet AMD and GA that, while their diseases sound similar and are somewhat related, they are in fact two different conditions that require different treatments?
Dr. Faia: I use terms and ideas that patients are familiar with, starting with the analogy of a patient who has high blood pressure and diabetes. I explain that although these conditions might arise from similar origins, they are distinct and therefore require unique treatments. There is no cure-all for retinal disease, the same way there isn’t one for hypertensive conditions in diabetic patients. Many patients seem to understand this concept once it’s explained to them this way.
Patients with both advanced forms of AMD sometimes forget that they have GA, and they are surprised to know it is present. I explain to them that we’ve been documenting it for years and that, now that a therapy is approved, we can act.
Real-World Cases: Routine Cases That Lead to Treatment, and Early Responses to Avacincaptad Pegol
Dr. Almeida: In this fairly straightforward case of GA, a patient presented to my clinic complaining of visual decline. OCT imaging and color fundus photography depicted a unifocal lesion with slight foveal involvement (Figure 9). This patient wanted to act quickly to delay future loss of vision and opted for monthly dosing with avacincaptad pegol. After three monthly doses, OCT imaging showed that GA progression was not evident (Figure 10). The patient was happy with the lack of disease progression and has reported a desire to continue monthly therapy.

Figure 9. A patient who presented with a complaint of visual decline showed a unifocal lesion nearing the fovea on OCT imaging (A) and color fundus photography (B).

Figure 10. After 3 monthly doses with avacincaptad pegol, this patient’s GA had not noticeably progressed on OCT imaging.
In a separate case, a patient was diagnosed with GA in March 2023, based partly on OCT imaging (Figure 11A). I observed limited foveal involvement. I asked them to return for several monitoring visits to assess the rate at which GA was progressing in this patient. The patient was amenable to treatment with avacincaptad pegol and wanted to initiate treatment despite the limited progression observed during the monitoring period. After three monthly doses of avacincaptad pegol, I noted limited changes in their eyes (Figure 11B).

Figure 11. OCT imaging on presentation was used in the diagnosis of GA (A). After 3 monitoring visits, the patient began treatment with avacincaptad pegol. OCT imaging after the third injection of anti-complement therapy showed that the patient’s disease had progressed very little (B).
When beginning treatment for GA, I ask that patients visit the clinic monthly for two reasons: to try to adhere as closely as possible to pivotal study protocols and to begin treatment with a course of loading doses. If patients report some subjective vision changes during a monitoring period, and imaging depicts anatomic morphology that could account for such changes, then I am confident that progression has occurred. If, however, no progression is evident based on imaging results, then I am open to continued monitoring unless the patient wants to pursue treatment. I have found that many patients with GA want to begin anti-complement therapy even if their vision is good and there is no evidence of rapid progression.
Dr. Riemann: GA is often characterized as a slow-moving disease, and monthly monitoring may be too frequent to track progression. Still, frequent monitoring visits serve a purpose: they allow patients and doctors to build rapport and trust and can create an opportunity for patients to receive education about their disease. That education can come in the form of patient-facing literature or direct interaction with a clinician. Our patients deserve space to make nuanced decisions, and the more information we give them, the better armed they are in their decision-making.
Dr. Faia: As Dr. Riemann mentioned earlier, chair time with GA patients leads to educated patients who make informed decisions—but it also significantly slows clinical throughput. Using a physician extender such as an optometrist could help clinicians effectively manage swelling patient rosters if GA treatments become a larger part of their practices. These physician extenders could help educate patients about the value of treatment, help them understand the burden of care versus the burden of potential disease progression, and work with caretakers to sort the logistics of office visits.
Dr. Almeida: At my clinic, we partner with a patient-facing optometrist who helps patients in the way Dr. Faia describes. I also collaborate with a retina specialist who handles high-volume routine cases, clearing the way for me to manage more complex ones. When the retina specialist and the optometrist at my clinic tackle GA patients together, we are able to accommodate a rather high patient volume.
Forecasting the Future of Care in GA
Dr. Almeida: What trends do you anticipate regarding GA therapy in the coming 12 to 18 months?
Dr. Faia: I think our clinics will become significantly busier as we learn how to assess and treat subsets of GA patients. Retina clinic managers and practitioners will need to find a way to manage this increased volume—and I’m not sure we have all the answers just yet.
Dr. Riemann: Artificial intelligence systems may allow us to identify characteristics of responders and non-responders to GA treatment, which could lead us toward the precision medicine of the future. Also, I think retina specialists will begin to optimize workflows to accommodate extra patient volume.
Dr. Almeida: I predict we will soon be able to provide patients with possible progression scenarios based on natural history studies. Imagine presenting a patient with their current FAF image and then showing them the likely progression that will occur without intervention versus the likely progression that would occur if they underwent treatment. This could allow patients to understand the options before them better than they already do.

Listen to "GA Options in Clinical Therapy" as a podcast series on New Retina Radio.
PART 1: Patient Selection and Treatment Strategies
PART 2: Real-World Cases in GA
1. Avacincaptad pegol prescribing information. Accessed April 21, 2024. Revised August 2023. Available at: https://www.accessdata.fda.gov/drugsatfda_docs/label/2023/217225s000lbl.pdf.






